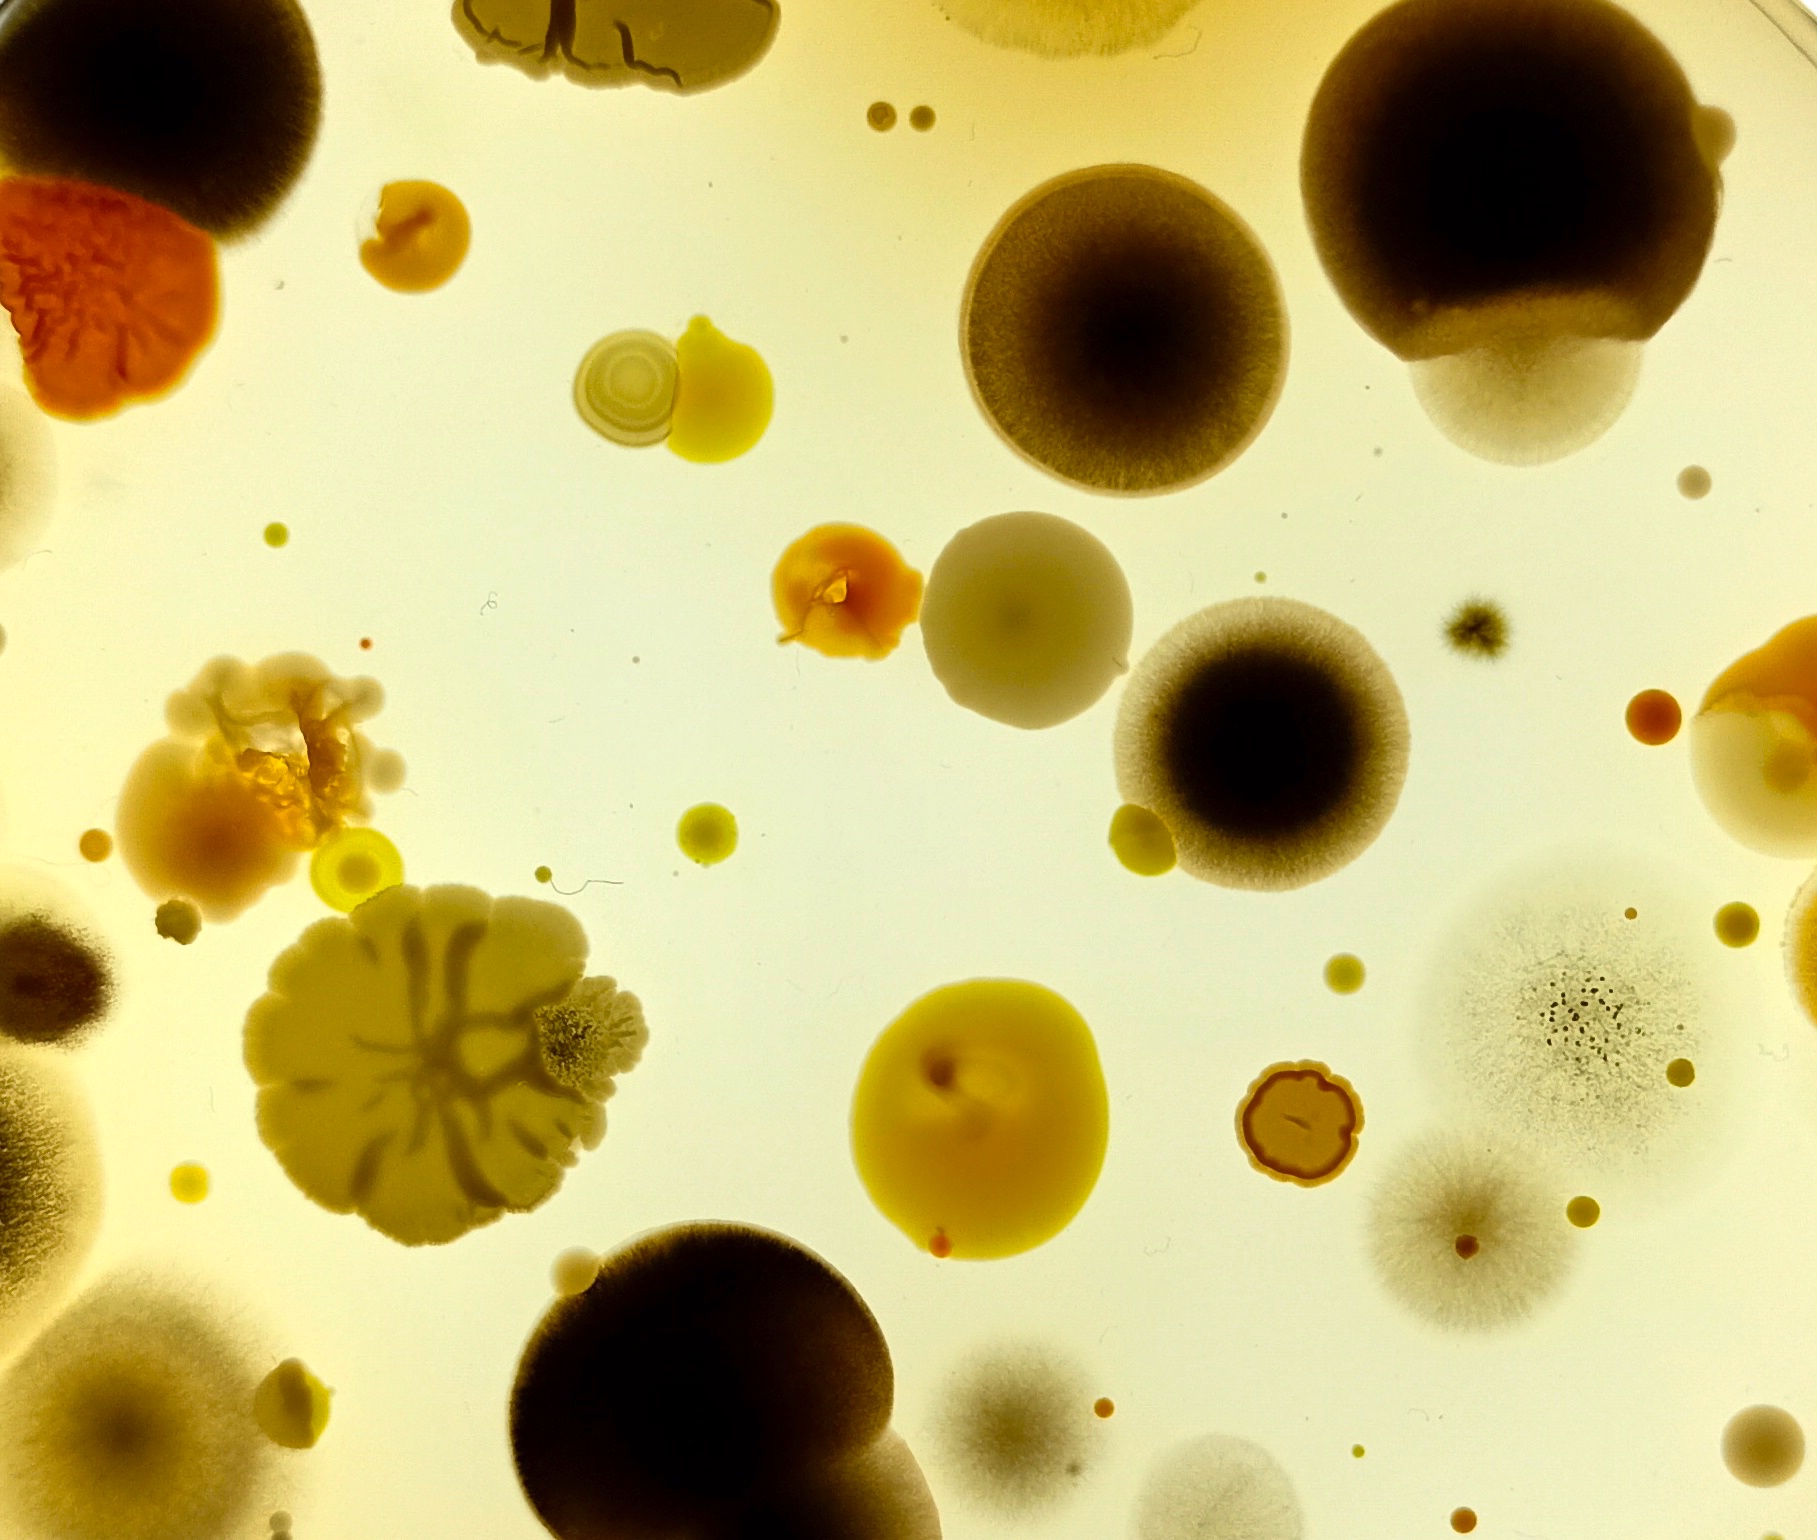
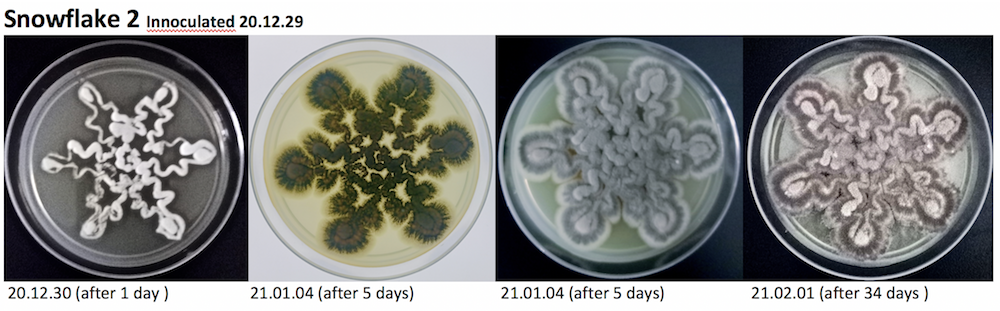
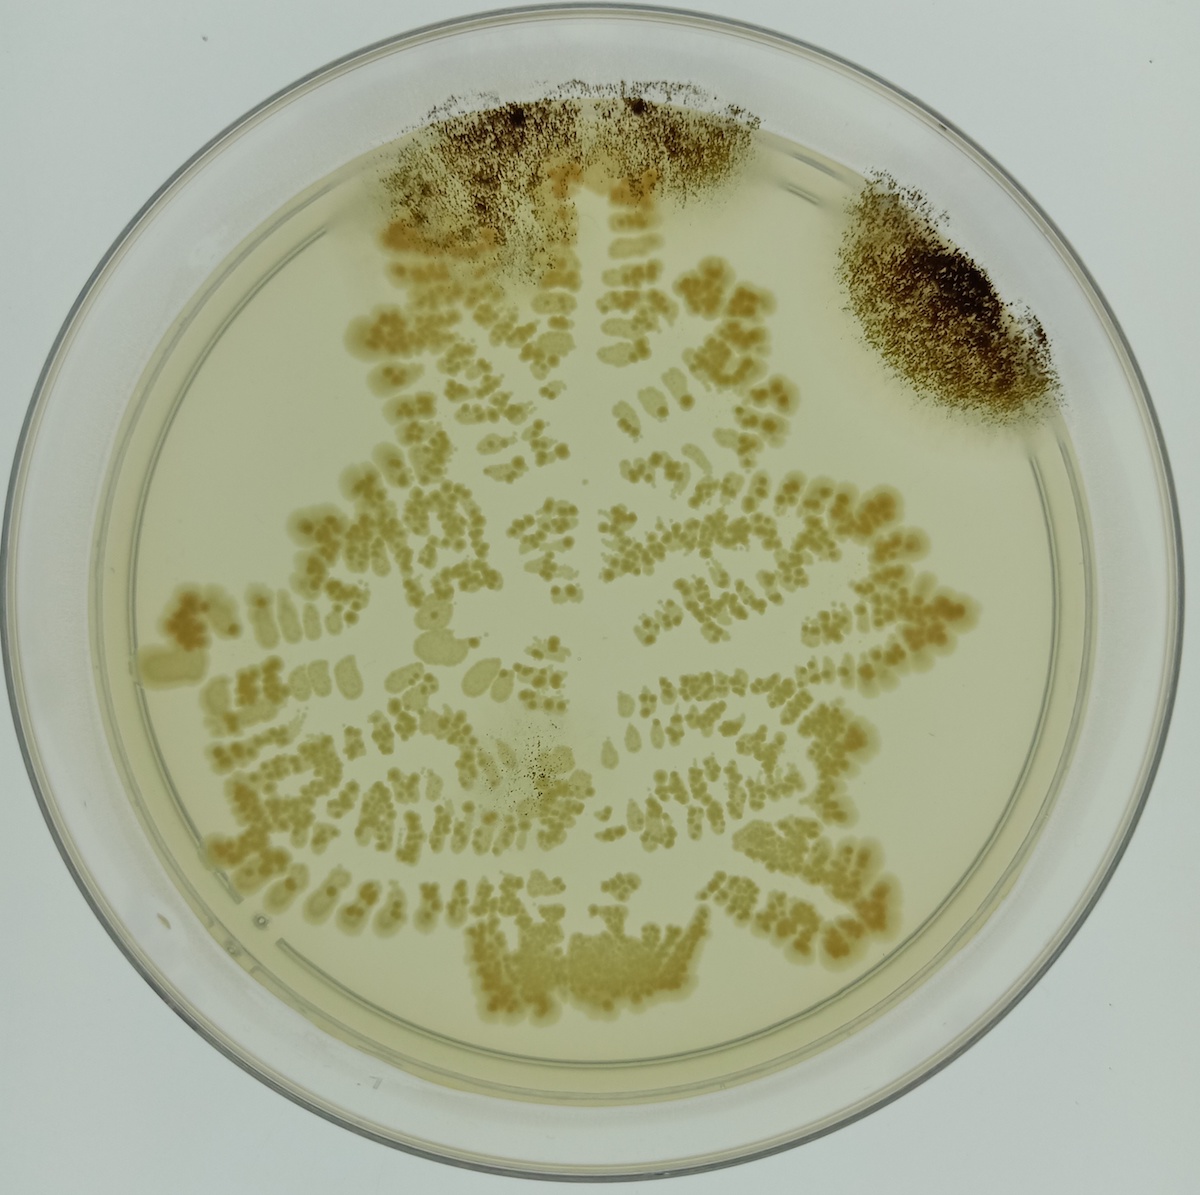

即将展出:
十一月 2024树的故事在成都–A4国际艺术驻留中心
十一月 2024 树:万物互联
十月 2024 来自西山的树的故事
九月 2024植物猎人胡君博士,“树的故事”工作坊特邀嘉宾
九月 2024蔗糖系列在沈阳“纸上·至上“展览中展出
八月 2024自然的呢喃——人与树的重新连接 – 策展文章
八月 2024“记忆宫殿树的故事”绘画展览,成都许燎源现代设计艺术博物馆
五月2024成都“树的故事”工作坊
四月 2024TEDXBEIXINQIAO 演讲
一月 2024聚会放映 2024年1月28日星期天举办了
2022 9月 谷山村中国农民丰收节暨大地艺术节
正在展出:
2022 9月 传粉者:北京西山鼓山乡村公园的再生材料雕塑
最新动态:
2022 年 6月-8月“月亮之约” For觅画廊,通州,北京
2022 年 1 月 来自爱尔兰的艺术家 ,线上展览 在线链接
2022 年 1 月清华大学精准医学研究院, EBM 中心
2021年12月“生命之律动”,西双版纳州美术馆,景洪
2021年12月“线性”,竞衡艺术空间,上海
2021年10月-11月“中国抽象艺术”,江苏泰州
2021年10月“相遇大运河”,通州新光大中心
2021年7月 “线性”,798朗空美术馆,北京
2021年7月“她的名字——存在”,半岛美术馆,威海
2021年6月“润物细无声·艺术与遗产新解构”,苏州耦园
2021年6月10日“万物有灵——多样之美” 艺术展与企业社会责任国际论坛,北京
2021年6月“第二步”(小型个人展),龙头井胡同JoyBeans Space,北京
2021年6月“天体世界:出逃旅行” 蓝色港湾KUN美术馆,北京
2021年3月4月 ART Beijing 2021
2020年12月 “艺术推动可持续未来” 中国企业社会责任国际学术研讨会, 北京泰富酒店
2020年9月“同生·由此及彼”,山东济宁市泗水等闲谷艺术粮仓美术馆
2020年7月 “沉默的爆破”,无锡外滩美术馆,江苏无锡, 7月11日至31日
2019年11月”中国 爱尔兰 MUSEu&m , 上海
*2019年11月装置中国—红房子首届国际户外装置创作营在乐山沙湾红房子开营 …开始阶段
*2019年8月*Gobi Heaven- August 戈壁。天堂-八月
*2019年7月”1919″ 爱尔兰 Sligo -Hamilton Gallery
*2019年5月“胜日寻芳“ 山东济宁市泗水等闲谷艺术粮仓美术馆
2019年5月-16日 爱尔兰大使馆布卢姆日的展览
2019年5月-6月 《一张棉花纸》 在宋庄东区玖层美术馆展出
*2019年4月-5月在匈牙利首都布达佩斯
*2019年4月”奥德赛——回归”群展2019年4月13日在东岳美术馆开幕。
*2018年11月-12月“地图与疆域”国际艺术邀请展 北京吉利学院
*2018年11月-12月“纸上·至上”展览,韩国光州市立美术馆北京创作中心
*2018, 10月“中欧国际当代艺术全球巡展·上海”
* 2018, 9月-10月“纸上·至上”展览,沈阳市拓•空间,
* 2018, 6月-11月诗人叶芝日,爱尔兰,斯莱戈(SLIGO),汉密尔顿艺术画廊
*2018年8月 淮阴艺术馆提名展,淮安市
*2018, 8月 “纸上·至上”展览, 鄂尔多斯,
*2018 , 6月30日 济南“国际抽象艺术展”
*2018 , 6月17 日 纸上•至上2018 在青岛,
*2018 , 5月20 日存在-国际女性艺术展,湖南长沙,
*2018 , 4月21 日延缓的时间,4月21日-29日,红门画廊,798艺术区
*2018 , 4月20 日 挖掘,,和画廊,来鹏高尔夫俱乐部
*2018年4月-12日 挖掘, , 展览,悦美术馆,北京798艺术区
*2018年2月-3月深圳观澜版画艺术区,5个星期驻地项目
*2018年1月28日-3月3日,《红&果》,流浪美术馆融空间,新年主题艺术展,北京中关村融科资讯中心
*2017年12月,中外视觉艺术湖南展,湖南长沙梅溪新天地梅溪书院.
*2017年12月末至2018年1月末, 《时间之外》主题艺术展, 北京中关村融科资讯中心
*2017年12月, 形质与叙事, 形质与叙事, 东岳美术馆
*2017年12月,广州新造当代艺术中心,纸上·至上 纸艺作品群展.
Upcoming Exhibitions:
* Gushan Rural Village Park Harvest Autumn 2022
Current Exhibition
Recent exhibitions:
2022 Moon Covenant For觅 gallery , Grasse Town , Beijing June- August
2022 Artists from Ireland (online) Sasse Museum of Art Pomona, CA, USA (catalogue link)
2022 Peoples’ Portraits EBM Centre, Tsinghua Uni Intelligent HealthCare, BJ
2021 Rhythm of Life Xishuangbanna Art Museum, Jinghong, Dec
2021 Linear Jingheng Art centre, Jinshan, Shanghai Dec
2021 Abstract China, Taizhou, Jiangsu Oct-Nov
2021 Meet the Grand Canal Xinguanda Centre Tongzhou, Oct
2021 Linear Langkong Art Museum 798, Beijing July
2021 Her Name – Existence Peninsula Art Museum, Weihai, July
2021 Silent and Soft -New Interpretations Suzhou classical Gardens June
2021 All things Bright CSR symposium Shangrila Hotel, Beijing June 10th
2021 The Second Step (mini solo) Joy Beans Space, Jiu Longtou hutong, June
* AstroWorld Kun Art Museum June 5 2021
*Portraits (solo) Joybeans Hou Hai 6.6-8.8
*River things Suzhou Zhenyuan garden UNESCO world Heritage Training and Research centre June 12 th
*Art Beijing 2021 Booth B28 Garden of Friendship
*“Art promotes a Sustainable Future” China CSR international symposium Dec 2020.
*Silent Explosion, Wuxi Bund Art Centre, Jiangsu, July 11-31 2020
* Sculpture project in HongFangzu , Shawan, Sichuan , begining phase Nov 2019
Current Exhibition
*China Ireland exhibition at MUSEU&m, near the Bund , Shanghai, Nov 29th 2019
* Sculpture project in HongFangzu , Shawan, Sichuan , begining phase Nov 2019
*1919 – Group Exhibition (Hamilton Gallery) in New York, Irish Consulate
*1919 – Group Exhibition Hamilton Gallery , Sligo , Ireland July – September
*Gobi Heaven Art Festival , Inner Mongolia , August 2019
*A piece of Cotton Paper 9th floor gallery Songzhuang June 15th
*”Winning the Day ‘ Granary Art Centre, SiShui , Shandong, May – June 2019
*Beyond the form of Art , Wick Art Centre , Budapest, Hungary may 2019
*Odyssey The Return ; group exhibition at Dong Yue Art Museum, Beijing in April
* Map and Territory Art IRRCA at Beijing Geely College Nov 20- Dec 20 2018
*Thousands of Sprouts, an experimental online exhibition – by Elizabeth Ross Nov 2018
* On Paper Supreme, Gwangju Art Museum Beijing Creative Centre Songzhuang Nov- Dec 2018
*China Europe Internaitional Contemporary Art Global Tour Shanghai Oct 2018
*An Irish Airman foresees his Death – Hamilton Gallery Sligo, Ireland June – Nov 2018
*On Paper Supreme, Extension Space, Shenyang, Liaoning, Sept 16th – Oct 21st 2018
*Artist Nomination Exhibition, Huaiyin art gallery, Huai ‘an shi, Jiangsu, July-Aug 2018
*On Paper Supreme, Ordos Culture and Art Centre , Inner Mongolia , Aug 17th – Sept 10th 2018
*International Abstract Art , ChungChuen College, Jinan, July 2018
* On Paper Supreme, QingDao , Tiantai Art Centre, June 2018
* Existence , International Feminist Art Exhibition, Mezzi Bookstore Art Space , Changsha
* Excavations 20 April-4th June He Gallery, Golf Club.
*’Mortgaged Time’ 21st- 29th April at Red Gate Gallery , 798 Beijing April 21st
*’Excavations’ 12-18th Enjoy Museum 798, Beijing preview 5 pm 12th April
* 5 week residency at Guanlan Printmaking base , Shenzhen (Feb-March 2018)
*Lunar New Year theme exhibition “Red Fruit” showing at Raycom IT centre, Zhongguancun, 28th Jan continues to March 3rd, organised by RoveArt , supporting the Female Protection Fund.
*Chinese & Foreign Visual Arts Hunan, at the Meixi Academy Book Complex, Changsha Dec 26th to Jan 26th 2018.
* ‘Beyond Time’ Raycom IT Centre, Zhongguangcun, Beijing Dec – Jan 27th 2018
*”Qualitative Phase and The Narrative” Beijing Film Academy Triennial Exhibition at Dong Yue Art Museum, Beijing, curated by Li Zhen till Dec 18th 2017…………………………………………….
 活生生的根在我手中醒来 在Luria –Bertani琼脂上发现灰尘
活生生的根在我手中醒来 在Luria –Bertani琼脂上发现灰尘 1.“生命的光II” 大肠埃希氏菌绿色荧光蛋白,玫瑰色考克氏菌,White M,LB琼脂上紫外线下
1.“生命的光II” 大肠埃希氏菌绿色荧光蛋白,玫瑰色考克氏菌,White M,LB琼脂上紫外线下 杨博士的培养皿:“生活就像一盒巧克力,你永远不知道会得到什么。”
杨博士的培养皿:“生活就像一盒巧克力,你永远不知道会得到什么。” 在当前新冠时代,微生物和病毒对我们来说有着全新的意义,因为我们正在努力实现全球复苏。我相信这种全新的有关感染的认识和知识也会影响到我们解读培养皿艺术作品的方式。
在当前新冠时代,微生物和病毒对我们来说有着全新的意义,因为我们正在努力实现全球复苏。我相信这种全新的有关感染的认识和知识也会影响到我们解读培养皿艺术作品的方式。 1 制作Luria Bertani生长培养基;对培养基高压灭菌;
1 制作Luria Bertani生长培养基;对培养基高压灭菌; 3 倒入培养皿,让其在紫外线下冷却和固化,有助于保持无菌环境。盖子略高于冷却凝胶可减少污染的机会,不过有时凝结的水珠会附着在培养皿上的盖子上,这种情况有时会导致凝胶污染。
3 倒入培养皿,让其在紫外线下冷却和固化,有助于保持无菌环境。盖子略高于冷却凝胶可减少污染的机会,不过有时凝结的水珠会附着在培养皿上的盖子上,这种情况有时会导致凝胶污染。 5 在用线环接种培养皿后,我发现培养基表面经常会被弄破。后来我尝试了无菌塑料环,这个工具更容易操作。当然,我打破了一些规则使用了无菌刷,甚至还用了打印块。
5 在用线环接种培养皿后,我发现培养基表面经常会被弄破。后来我尝试了无菌塑料环,这个工具更容易操作。当然,我打破了一些规则使用了无菌刷,甚至还用了打印块。 中科院过程工程所科学家穆廷桢博士、Nadia Samak博士、马丽霞老师、我、邢建民教授和杨茂华博士,2020年12月首次参观一零一中学园艺中心
中科院过程工程所科学家穆廷桢博士、Nadia Samak博士、马丽霞老师、我、邢建民教授和杨茂华博士,2020年12月首次参观一零一中学园艺中心 免疫之年,灯箱下Luria Bertani凝胶上的CW,Niamh Cunningham瑞莲 2021
免疫之年,灯箱下Luria Bertani凝胶上的CW,Niamh Cunningham瑞莲 2021